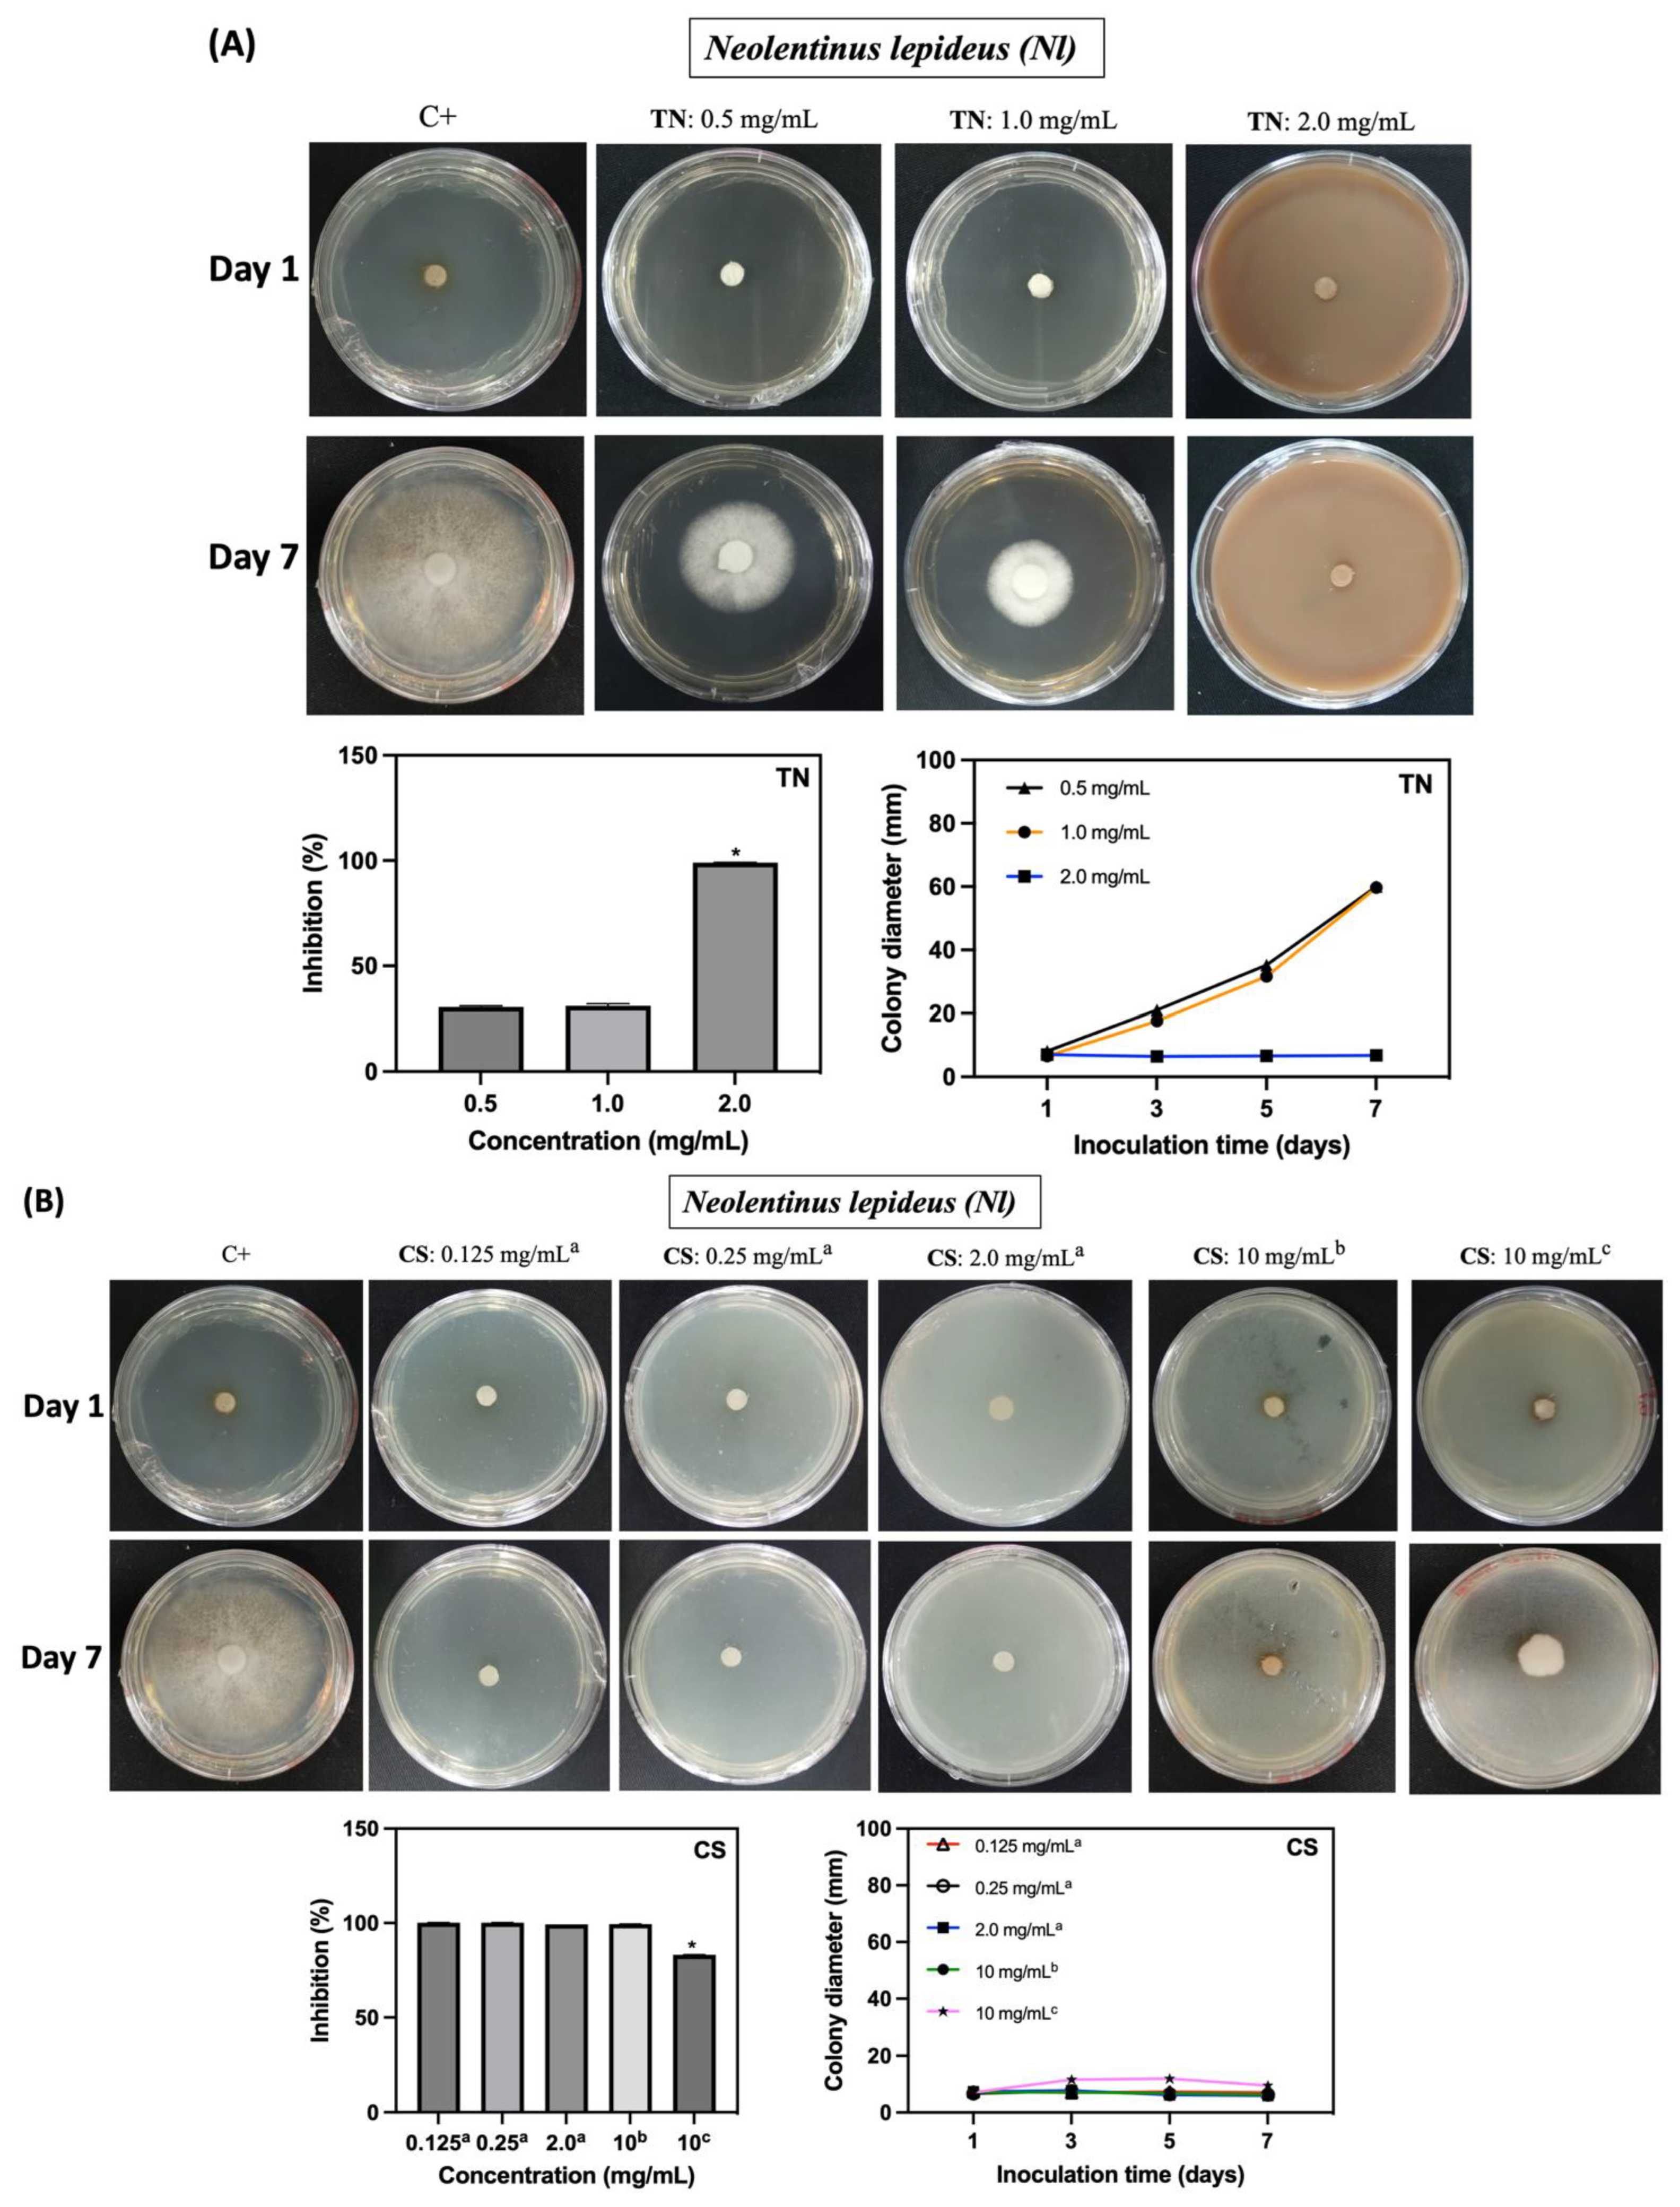
Ijms 25 10899 g006a Ijms 25 10899 g006a
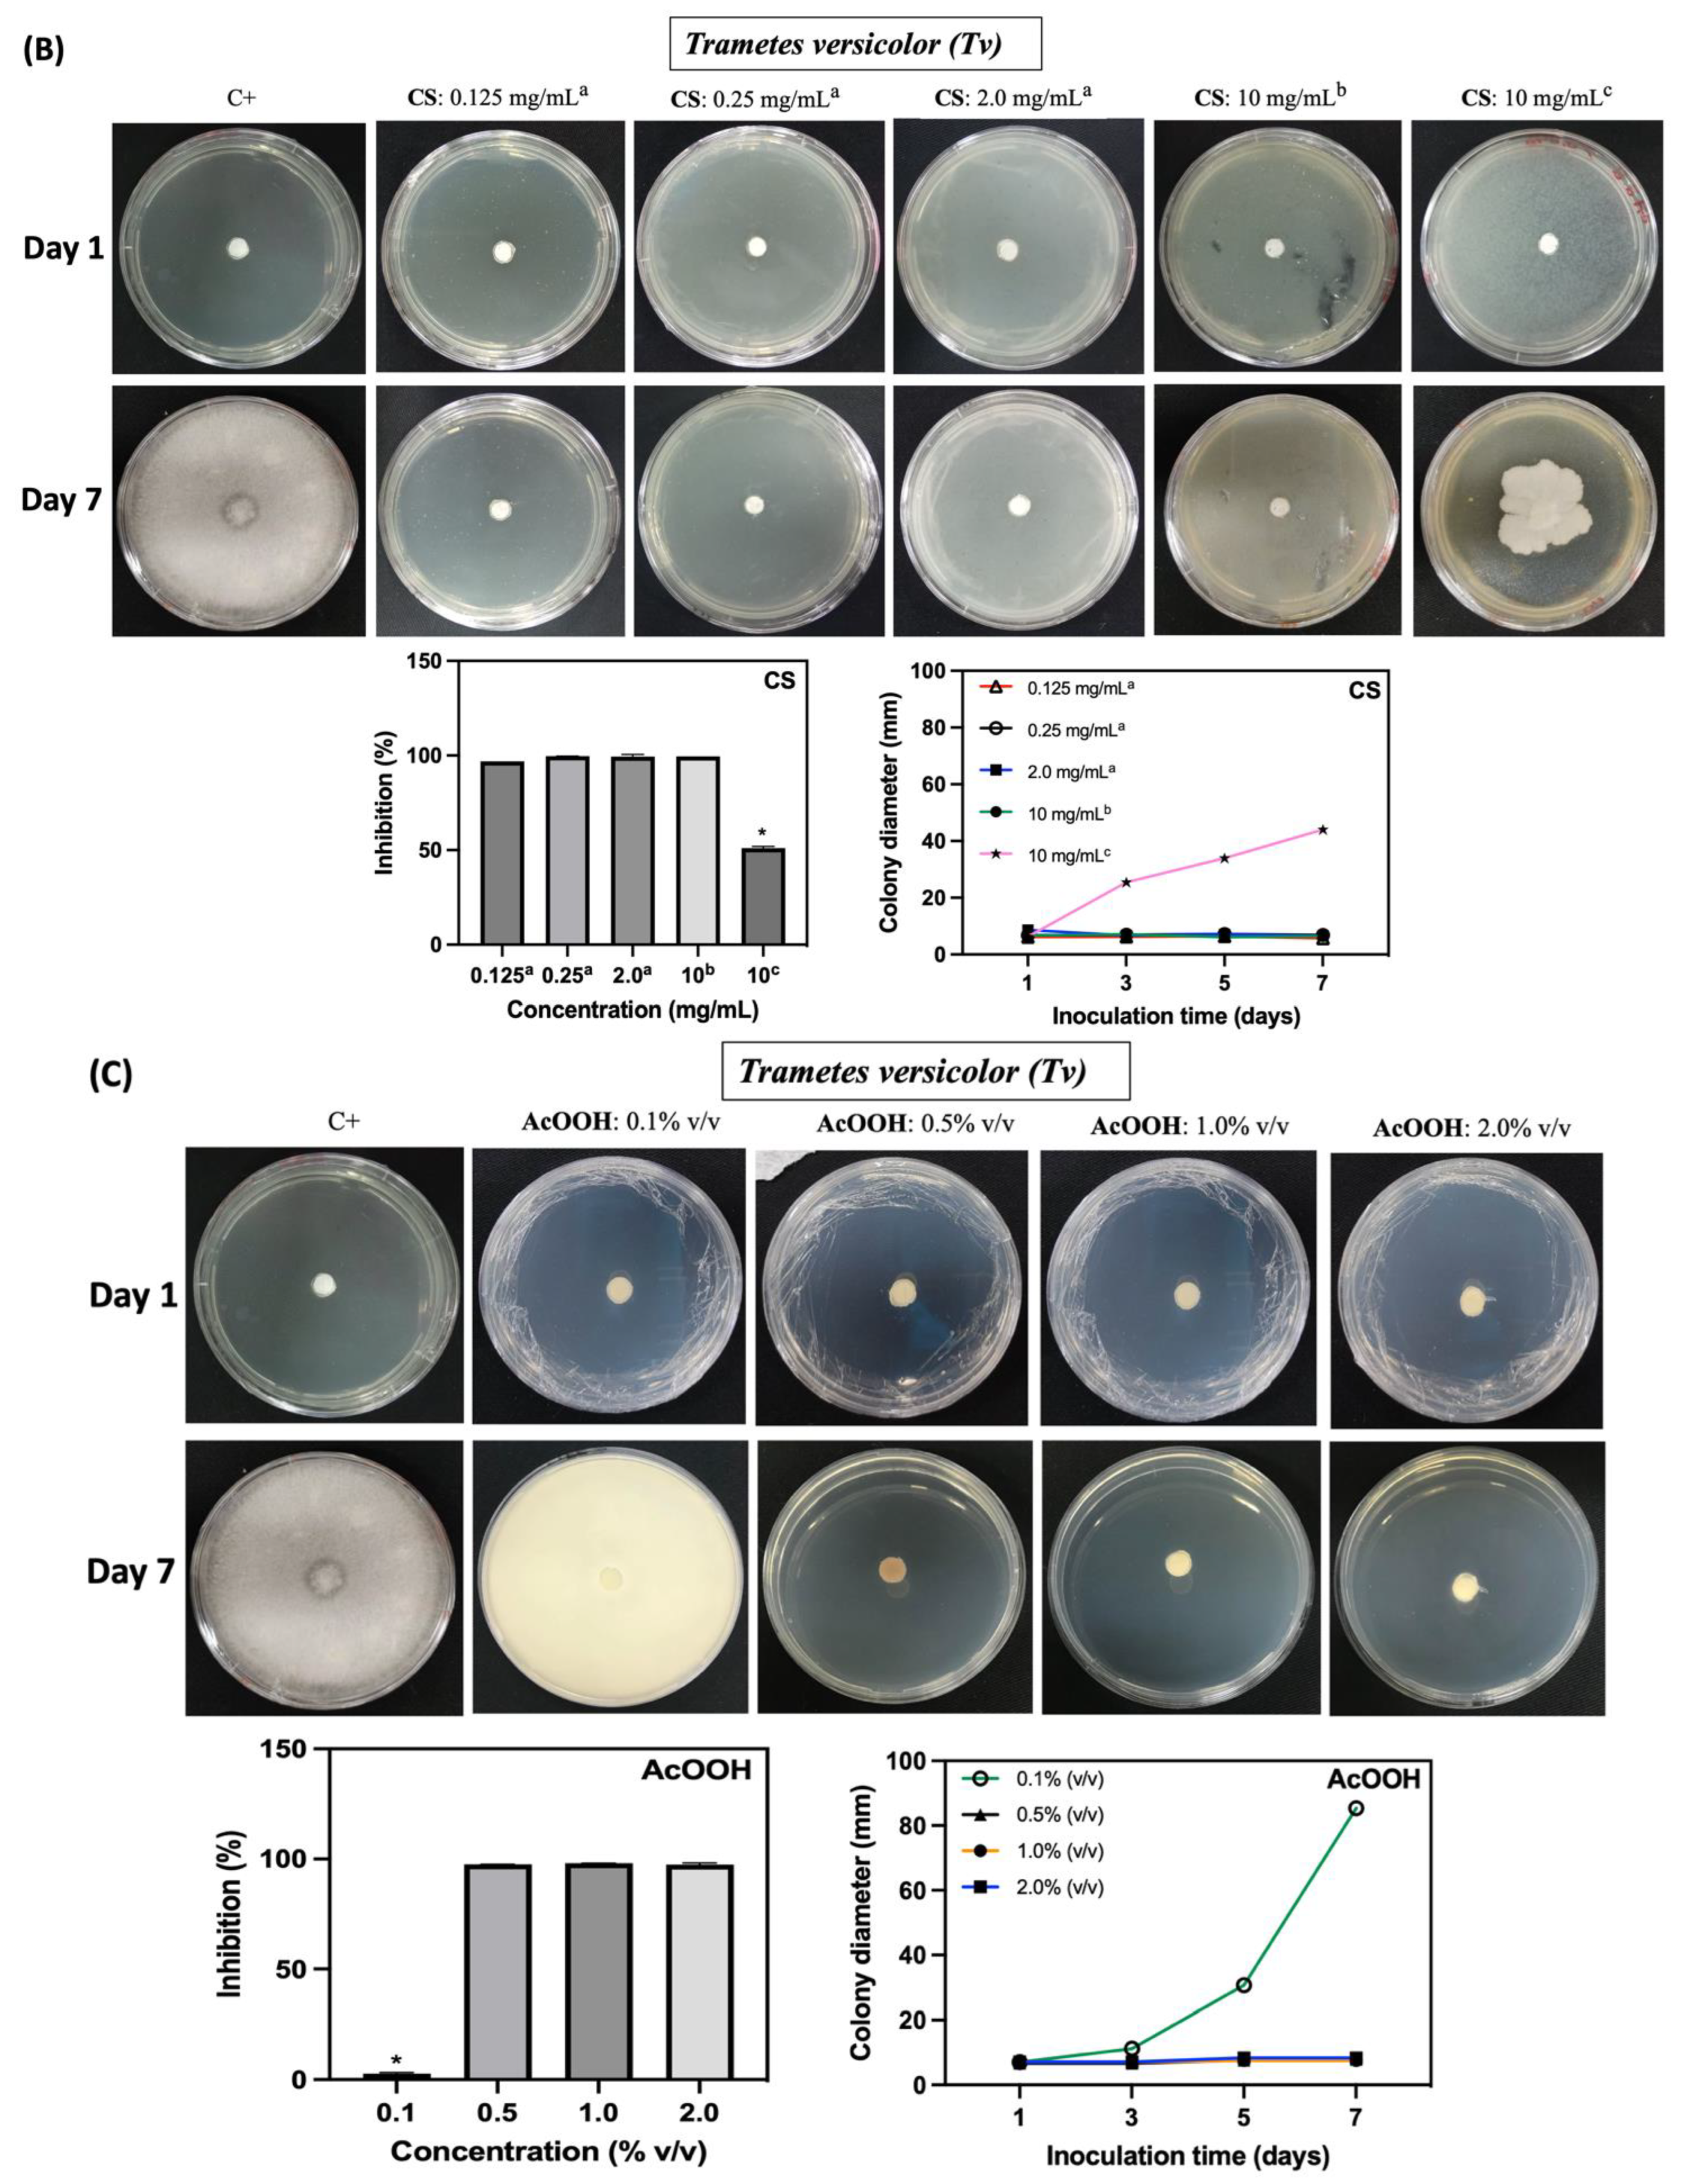
Ijms 25 10899 g007b Ijms 25 10899 g007b

Ultra-Pressurized Deposition of Hydrophobic Chitosan Surface Coating on Wood for Fungal Resistance
Abstract
1. Introduction
2. Results and Discussion
2.1. Characterization of the Surface Coatings Deposited on Wood
2.2. Fungicidal Activity of the Polymers against Neolentinus lepideus and Trametes versicolor
2.3. Antifungal Activity In Vivo
2.4. Leaching
3. Materials and Methods
3.1. Materials
3.2. Surface Coatings Deposited on Wood through Ultra-Pressurization
3.3. Characterization
3.4. Antimicrobial Tests with Wood Rot-Causing Fungi
3.4.1. Fungal Material
3.4.2. In Vitro Antifungal Activity of Biopolymers and Acetic Acid Solutions
3.4.3. In Vivo Preservative Treatment of Wood
3.5. Leaching Assay
3.6. Statistical Analysis
4. Conclusions
Supplementary Materials
Author Contributions
Funding
Institutional Review Board Statement
Informed Consent Statement
Data Availability Statement
Acknowledgments
Conflicts of Interest
References
- Bossardi Dias, K.; Marques Barreiros, R. Preservative Treatments on Wood and Their Effects on Metal Fasteners. In Engineered Wood Products for Construction; Gong, M., Ed.; IntechOpen: London, UK, 2022; ISBN 978-1-83962-771-2. [Google Scholar]
- De Avila Delucis, R.; Gonzales De Cademartori, P.H.; Missio, A.L.; Alberto Gatto, D. Decay Resistance of Four Fast-Growing Eucalypts Wood Exposed to Three Types of Fields. Maderas Cienc. Tecnol. 2016, 18, 33–42. [Google Scholar] [CrossRef]
- Barnes, H.M. Wood: Preservative Treated. In Encyclopedia of Materials: Science and Technology; Elsevier: Amsterdam, The Netherlands, 2001; pp. 9683–9688. ISBN 978-0-08-043152-9. [Google Scholar]
- Barbero-López, A.; Akkanen, J.; Lappalainen, R.; Peräniemi, S.; Haapala, A. Bio-Based Wood Preservatives: Their Efficiency, Leaching and Ecotoxicity Compared to a Commercial Wood Preservative. Sci. Total Environ. 2021, 753, 142013. [Google Scholar] [CrossRef] [PubMed]
- Lowden, L.; Hull, T. Flammability Behaviour of Wood and a Review of the Methods for Its Reduction. Fire Sci. Rev. 2013, 2, 4. [Google Scholar] [CrossRef]
- Jain, S.H.; Nagaveni, H.C.; Vijayalakshmi, G. Effect of Leaf and Bark Extracts of Cleistanthus collinus (Benth. & Hook) and Prosopis juliflora (Sw.) DC in Combination with Inorganic Compounds against Wood Decay Fungi. J. Indian Acad. Wood Sci. 2011, 8, 198–200. [Google Scholar] [CrossRef]
- Tascioglu, C.; Yalcin, M.; Sen, S.; Akcay, C. Antifungal Properties of Some Plant Extracts Used as Wood Preservatives. Int. Biodeterior. Biodegrad. 2013, 85, 23–28. [Google Scholar] [CrossRef]
- Yildiz, Ü.C.; Kilic, C.; Gürgen, A.; Yildiz, S. Possibility of Using Lichen and Mistletoe Extracts as Potential Natural Wood Preservative. Maderas Cienc. Tecnol. 2020, 22, 179–188. [Google Scholar] [CrossRef]
- Brocco, V.F.; Paes, J.B.; Costa, L.G.D.; Brazolin, S.; Arantes, M.D.C. Potential of Teak Heartwood Extracts as a Natural Wood Preservative. J. Clean. Prod. 2017, 142, 2093–2099. [Google Scholar] [CrossRef]
- Woźniak, M.; Kwaśniewska-Sip, P.; Waśkiewicz, A.; Cofta, G.; Ratajczak, I. The Possibility of Propolis Extract Application in Wood Protection. Forests 2020, 11, 465. [Google Scholar] [CrossRef]
- Barbero-López, A. Antifungal Activity of Several Vegetable Origin Household Waste Extracts Against Wood-Decaying Fungi In Vitro. Waste Biomass Valorization 2021, 12, 1237–1241. [Google Scholar] [CrossRef]
- Singh, T.; Singh, A.P. A Review on Natural Products as Wood Protectant. Wood Sci. Technol. 2012, 46, 851–870. [Google Scholar] [CrossRef]
- Sen, S.; Tascioglu, C.; Tırak, K. Fixation, Leachability, and Decay Resistance of Wood Treated with Some Commercial Extracts and Wood Preservative Salts. Int. Biodeterior. Biodegrad. 2009, 63, 135–141. [Google Scholar] [CrossRef]
- Tomak, E.D.; Gonultas, O. The Wood Preservative Potentials of Valonia, Chestnut, Tara and Sulphited Oak Tannins. J. Wood Chem. Technol. 2018, 38, 183–197. [Google Scholar] [CrossRef]
- Broda, M. Natural Compounds for Wood Protection against Fungi—A Review. Molecules 2020, 25, 3538. [Google Scholar] [CrossRef] [PubMed]
- Eikenes, M.; Alfredsen, G.; Christensen, B.E.; Militz, H.; Solheim, H. Comparison of Chitosans with Different Molecular Weights as Possible Wood Preservatives. J. Wood Sci. 2005, 51, 387–394. [Google Scholar] [CrossRef]
- Martins, A.F.; Vlcek, J.; Wigmosta, T.; Hedayati, M.; Reynolds, M.M.; Popat, K.C.; Kipper, M.J. Chitosan/Iota-Carrageenan and Chitosan/Pectin Polyelectrolyte Multilayer Scaffolds with Antiadhesive and Bactericidal Properties. Appl. Surf. Sci. 2020, 502, 144282. [Google Scholar] [CrossRef]
- Kaya, M.; Baran, T.; Erdoğan, S.; Menteş, A.; Özüsağlam, M.A.; Çakmak, Y.S. Physicochemical comparison of chitin and chitosan obtained from larvae and adult Colorado potato beetle (Leptinotarsa decemlineata). Mater. Sci. Eng. C 2014, 45, 72–81. [Google Scholar] [CrossRef] [PubMed]
- Goy, R.C.; Britto, D.D.; Assis, O.B.G. A Review of the Antimicrobial Activity of Chitosan. Polímeros 2009, 19, 241–247. [Google Scholar] [CrossRef]
- El-Gamal, R.; Nikolaivits, E.; Zervakis, G.I.; Abdel-Maksoud, G.; Topakas, E.; Christakopoulos, P. The Use of Chitosan in Protecting Wooden Artifacts from Damage by Mold Fungi. Electron. J. Biotechnol. 2016, 24, 70–78. [Google Scholar] [CrossRef]
- Alorbu, C.; Cai, L. Fungal Resistance and Leachability of Genipin-Crosslinked Chitosan Treated Wood. Int. Biodeterior. Biodegrad. 2022, 169, 105378. [Google Scholar] [CrossRef]
- Vilsinski, B.H.; De Oliveira, A.C.; Souza, P.R.; Martins, A.F. Polysaccharide-Based Polyelectrolyte Multilayers Fabricated via Layer-by-Layer Approach: From Preparation to Applications. Prog. Org. Coat. 2024, 196, 108720. [Google Scholar] [CrossRef]
- Yordanov, D.G.; Angelova, G.V. High Pressure Processing for Foods Preserving. Biotechnol. Biotechnol. Equip. 2010, 24, 1940–1945. [Google Scholar] [CrossRef]
- Dumay, E.; Chevalier-Lucia, D.; Picart-Palmade, L.; Benzaria, A.; Gràcia-Julià, A.; Blayo, C. Technological Aspects and Potential Applications of (Ultra) High-Pressure Homogenisation. Trends Food Sci. Technol. 2013, 31, 13–26. [Google Scholar] [CrossRef]
- Li, Y.; Bao, L.; Song, B.; Han, J.; Li, H.; Zhao, F.; Liu, H. A New Benzoquinone and a New Benzofuran from the Edible Mushroom Neolentinus Lepideus and Their Inhibitory Activity in NO Production Inhibition Assay. Food Chem. 2013, 141, 1614–1618. [Google Scholar] [CrossRef] [PubMed]
- Schwarze, F.W.M.R. Wood Decay under the Microscope. Fungal Biol. Rev. 2007, 21, 133–170. [Google Scholar] [CrossRef]
- Zhang, J.; Meng Markillie, L.; Mitchell, H.D.; Gaffrey, M.J.; Orr, G.; Schilling, J.S. Distinctive Carbon Repression Effects in the Carbohydrate-Selective Wood Decay Fungus Rhodonia Placenta. Fungal Genet. Biol. 2022, 159, 103673. [Google Scholar] [CrossRef]
- Sabino, R.M.; Mondini, G.; Kipper, M.J.; Martins, A.F.; Popat, K.C. Tanfloc/Heparin Polyelectrolyte Multilayers Improve Osteogenic Differentiation of Adipose-Derived Stem Cells on Titania Nanotube Surfaces. Carbohydr. Polym. 2021, 251, 117079. [Google Scholar] [CrossRef]
- Raafat, D.; Sahl, H.-G. Chitosan and Its Antimicrobial Potential—A Critical Literature Survey. Microb. Biotechnol. 2009, 2, 186–201. [Google Scholar] [CrossRef] [PubMed]
- Rimoli, C.V.; de Oliveira Pedro, R.; Miranda, P.B. Interaction Mechanism of Chitosan Oligomers in Pure Water with Cell Membrane Models Studied by SFG Vibrational Spectroscopy. Colloids Surf. B Biointerfaces 2022, 219, 112782. [Google Scholar] [CrossRef]
- Nandi, S.; Guha, P. Modelling the Effect of Guar Gum on Physical, Optical, Barrier and Mechanical Properties of Potato Starch Based Composite Film. Carbohydr. Polym. 2018, 200, 498–507. [Google Scholar] [CrossRef]
- Kolya, H.; Kang, C.-W. Polyvinyl Acetate/Reduced Graphene Oxide-Poly (Diallyl Dimethylammonium Chloride) Composite Coated Wood Surface Reveals Improved Hydrophobicity. Prog. Org. Coat. 2021, 156, 106253. [Google Scholar] [CrossRef]
- Inhibition Effects of Dilute-Acid Prehydrolysate of Corn Stover on Enzymatic Hydrolysis of Solka Floc|SpringerLink. Available online: https://link.springer.com/article/10.1007/s12010-011-9355-3 (accessed on 31 July 2023).
- León Peláez, A.M.; Serna Cataño, C.A.; Quintero Yepes, E.A.; Gamba Villarroel, R.R.; De Antoni, G.L.; Giannuzzi, L. Inhibitory Activity of Lactic and Acetic Acid on Aspergillus Flavus Growth for Food Preservation. Food Control 2012, 24, 177–183. [Google Scholar] [CrossRef]
- López, M.J.; Nichols, N.N.; Dien, B.S.; Moreno, J.; Bothast, R.J. Isolation of Microorganisms for Biological Detoxification of Lignocellulosic Hydrolysates. Appl. Microbiol. Biotechnol. 2004, 64, 125–131. [Google Scholar] [CrossRef] [PubMed]
- Kannisto, M.S.; Mangayil, R.K.; Shrivastava-Bhattacharya, A.; Pletschke, B.I.; Karp, M.T.; Santala, V.P. Metabolic Engineering of Acinetobacter baylyi ADP1 for Removal of Clostridium butyricum Growth Inhibitors Produced from Lignocellulosic Hydrolysates. Biotechnol. Biofuels 2015, 8, 198. [Google Scholar] [CrossRef]
- Tsai, C.; Mitton, K.P.; Johnson, B.F. Acetate Assimilation by the Fission Yeast, Schizosaccharomyces Pombe. Biochem. Cell Biol. 1989, 67, 464–467. [Google Scholar] [CrossRef]
- Schneider, H. Selective Removal of Acetic Acid from Hardwood-Spent Sulfite Liquor Using a Mutant Yeast. Enzym. Microb. Technol. 1996, 19, 94–98. [Google Scholar] [CrossRef]
- Saadat, S.; Rawtani, D.; Braganza, V. Antimicrobial Activity of Chitosan Film Containing Nanocomposite of Trachyspermum ammi (Ajwain) Seed Oil Loaded Halloysite Nanotubes against Foodborne Pathogenic Microorganisms. Appl. Clay Sci. 2022, 226, 106554. [Google Scholar] [CrossRef]
- Martins, A.F.; Facchi, S.P.; Follmann, H.D.M.; Pereira, A.G.B.; Rubira, A.F.; Muniz, E.C. Antimicrobial Activity of Chitosan Derivatives Containing N-Quaternized Moieties in Its Backbone: A Review. Int. J. Mol. Sci. 2014, 15, 20800–20832. [Google Scholar] [CrossRef] [PubMed]
- Fajardo, A.; Pereira, A.; Martins, A.; Paulino, A.; Muniz, E.; Hsieh, Y.-L. Chitin and Chitosan-Based (NANO) Composites. In Handbook of Composites from Renewable Materials; Scrivener Publishing LLC: Beverly, MA, USA, 2016; pp. 671–700. ISBN 978-1-119-22381-8. [Google Scholar]
- Machado, B.R.; Roberto, S.B.; Bonafé, E.G.; Camargo, S.E.A.; Camargo, C.H.R.; Popat, K.C.; Kipper, M.J.; Martins, A.F. Chitosan Imparts Better Biological Properties for Poly(ε-Caprolactone) Electrospun Membranes than Dexamethasone. J. Braz. Chem. Soc. 2019, 30, 1741–1750. [Google Scholar] [CrossRef]
- Arslan, B.; Soyer, A. Effects of Chitosan as a Surface Fungus Inhibitor on Microbiological, Physicochemical, Oxidative and Sensory Characteristics of Dry Fermented Sausages. Meat Sci. 2018, 145, 107–113. [Google Scholar] [CrossRef]
- Xing, K.; Zhu, X.; Peng, X.; Qin, S. Chitosan Antimicrobial and Eliciting Properties for Pest Control in Agriculture: A Review. Agron. Sustain. Dev. 2015, 35, 569–588. [Google Scholar] [CrossRef]
- Barbosa, H.F.G.; Francisco, D.S.; Ferreira, A.P.G.; Cavalheiro, É.T.G. A New Look towards the Thermal Decomposition of Chitins and Chitosans with Different Degrees of Deacetylation by Coupled TG-FTIR. Carbohydr. Polym. 2019, 225, 115232. [Google Scholar] [CrossRef] [PubMed]
- Raj, V.; Kim, Y.; Kim, Y.-G.; Lee, J.-H.; Lee, J. Chitosan-Gum Arabic Embedded Alizarin Nanocarriers Inhibit Biofilm Formation of Multispecies Microorganisms. Carbohydr. Polym. 2022, 284, 118959. [Google Scholar] [CrossRef]
- Costa, E.M.; Silva, S.; Veiga, M.; Vicente, S.; Tavaria, F.K.; Pintado, M.E. Investigation of Chitosan’s Antibacterial Activity against Vancomycin Resistant Microorganisms and Their Biofilms. Carbohydr. Polym. 2017, 174, 369–376. [Google Scholar] [CrossRef] [PubMed]
- Mecanismos de Resistência de Candida albicans aos Antifúngicos Anfotericina B, Fluconazol e Caspofungina. Available online: https://www.rbac.org.br/artigos/mecanismos-de-resistencia-de-candida-albicans-aos-antifungicos-anfotericina-b-fluconazol-e-caspofungina/ (accessed on 31 July 2023).
- Rodríguez, A.B.F.; Menéndez, D.C.; Delgado, E.O.; Díaz, O.L.; Pino, J.C.C. Evaluation of Chitosan as an Inhibitor of Soil-Borne Pathogens and as an Elicitor of Defence Markers and Resistance in Tobacco Plants. Span. J. Agric. Res. 2007, 5, 533–541. [Google Scholar] [CrossRef]
- Elagamey, E.; Abdellatef, M.A.E.; Arafat, M.D.Y. Proteomic Insights of Chitosan Mediated Inhibition of Fusarium oxysporum f. Sp. Cucumerinum. J. Proteom. 2022, 260, 104560. [Google Scholar] [CrossRef]
- Ren, J.; Tong, J.; Li, P.; Huang, X.; Dong, P.; Ren, M. Chitosan Is an Effective Inhibitor against Potato Dry Rot Caused by Fusarium oxysporum. Physiol. Mol. Plant Pathol. 2021, 113, 101601. [Google Scholar] [CrossRef]
- Alburquenque, C.; Bucarey, S.A.; Neira-Carrillo, A.; Urzúa, B.; Hermosilla, G.; Tapia, C.V. Antifungal Activity of Low Molecular Weight Chitosan against Clinical Isolates of Candida spp. Med. Mycol. 2010, 48, 1018–1023. [Google Scholar] [CrossRef]
- Younes, I.; Rinaudo, M. Chitin and chitosan preparation from marine sources. Structure, properties and applications. Mar. Drugs 2015, 13, 1133–1174. [Google Scholar] [CrossRef]
- Garcia, L.G.S.; De Melo Guedes, G.M.; Fonseca, X.M.Q.C.; Pereira-Neto, W.A.; Castelo-Branco, D.S.C.M.; Sidrim, J.J.C.; De Aguiar Cordeiro, R.; Rocha, M.F.G.; Vieira, R.S.; Brilhante, R.S.N. Antifungal Activity of Different Molecular Weight Chitosans against Planktonic Cells and Biofilm of Sporothrix Brasiliensis. Int. J. Biol. Macromol. 2020, 143, 341–348. [Google Scholar] [CrossRef]
- Verlee, A.; Mincke, S.; Stevens, C.V. Recent Developments in Antibacterial and Antifungal Chitosan and Its Derivatives. Carbohydr. Polym. 2017, 164, 268–283. [Google Scholar] [CrossRef]
- Dhawale, P.V.; Vineeth, S.K.; Gadhave, R.V.; Fatima, M.J.J.; Supekar, M.V.; Thakur, V.K.; Raghavan, P. Tannin as a Renewable Raw Material for Adhesive Applications: A Review. Mater. Adv. 2022, 3, 3365–3388. [Google Scholar] [CrossRef]
- Suriyaprom, S.; Mosoni, P.; Leroy, S.; Kaewkod, T.; Desvaux, M.; Tragoolpua, Y. Antioxidants of Fruit Extracts as Antimicrobial Agents against Pathogenic Bacteria. Antioxidants 2022, 11, 602. [Google Scholar] [CrossRef] [PubMed]
- Mila, I.; Scalbert, A.; Expert, D. Iron Withholding by Plant Polyphenols and Resistance to Pathogens and Rots. Phytochemistry 1996, 42, 1551–1555. [Google Scholar] [CrossRef]
- Ucella-Filho, J.G.M.; da Freire, A.S.M.; Carréra, J.C.; Lucas, F.M.F.; Zucolotto, S.M.; Dias Júnior, A.F.; Mori, F.A. Tannin-Rich Bark Extract of Plants as a Source of Antimicrobial Bioactive Compounds: A Bibliometric Analysis. S. Afr. J. Bot. 2022, 150, 1038–1050. [Google Scholar] [CrossRef]
- Wrońska, N.; Katir, N.; Nowak-Lange, M.; El Kadib, A.; Lisowska, K. Biodegradable Chitosan-Based Films as an Alternative to Plastic Packaging. Foods 2023, 12, 3519. [Google Scholar] [CrossRef]
- Malerba, M.; Cerana, R. Recent Advances of Chitosan Applications in Plants. Polymers 2018, 10, 118. [Google Scholar] [CrossRef]
- Münstermann, N.; Weichold, O. Chitosan Itaconate Based Water- and Stain-Repellent Coatings for Wood. Prog. Org. Coat. 2024, 194, 108630. [Google Scholar] [CrossRef]
- Oliveira, J.T.D.; Tomasello, M.; Silva, J.D.C. Resistência Natural Da Madeira de Sete Espécies de Eucalipto Ao Apodrecimento. Rev. Árvore 2005, 29, 993–998. [Google Scholar] [CrossRef][Green Version]
- Facchi, S.P.; Souza, P.R.; De Almeida, D.A.; Madruga, L.Y.C.; Rosseto, P.; De Carvalho Nunes, W.M.; Kipper, M.J.; Martins, A.F.; Cardozo-Filho, L. Surface Coatings Based on Chitosan and Tannins Applied in the in Vivo Prevention of Corn Streak Disease. Chem. Eng. J. 2023, 477, 147003. [Google Scholar] [CrossRef]
- Sacco, F.S.; Cardozo-Filho, L.; Massa, T.B.; Feihrmann, A.C.; Abrantes, K.K.B. Unidade de Ultra Pressurização para Impregnação e Esterelização de Amostras em Meio Liquído. Patent BR 20 2020 014906 2, 22 July 2020. [Google Scholar]
- Macías-Almazán, A.; Lois-Correa, J.A.; Domínguez-Crespo, M.A.; López-Oyama, A.B.; Torres-Huerta, A.M.; Brachetti-Sibaja, S.B.; Rodríguez-Salazar, A.E. Dataset of Operating Conditions to Isolate Cellulose Nanocrystalline from Sugarcane Bagasse and Pinewood Sawdust as Possible Material to Fabricate Polymer Electrolyte Membranes. Data Brief 2020, 30, 105597. [Google Scholar] [CrossRef] [PubMed]
- De Oliveira, A.C.; Madruga, L.Y.C.; Chevallier, P.; Copes, F.; Mantovani, D.; Vilsinski, B.H.; Popat, K.C.; Kipper, M.J.; Souza, P.R.; Martins, A.F. Polyphenolic Tannin-Based Polyelectrolyte Multilayers on Poly(Vinyl Chloride) for Biocompatible and Antiadhesive Coatings with Antimicrobial Properties. Prog. Org. Coat. 2024, 194, 108629. [Google Scholar] [CrossRef]
- Souza, P.R.; Vilsinski, B.H.; de Oliveira, A.C.; Berton, S.B.R.; Madruga, L.Y.C.; Schrekker, H.S.; Radovanovic, E.; Kipper, M.J.; Martins, A.F.; Muniz, E.C. Poly(Ethylene Terephthalate) Films Coated with Antimicrobial Gelatin/Chondroitin Sulfate Polyelectrolyte Multilayers Containing Ionic Liquids. Prog. Org. Coat. 2022, 170, 106997. [Google Scholar] [CrossRef]
- Facchi, S.P.; de Oliveira, A.C.; Bezerra, E.O.T.; Vlcek, J.; Hedayati, M.; Reynolds, M.M.; Kipper, M.J.; Martins, A.F. Polycationic Condensed Tannin/Polysaccharide-Based Polyelectrolyte Multilayers Prevent Microbial Adhesion and Proliferation. Eur. Polym. J. 2020, 130, 109677. [Google Scholar] [CrossRef]
- da Silva Bruni, A.R.; de Souza Alves Friedrichsen, J.; de Jesus, G.A.M.; da Silva Alves, E.; da Costa, J.C.M.; Souza, P.R.; de Oliveira Santos Junior, O.; Bonafe, E.G. Characterization and Application of Active Films Based on Commercial Polysaccharides Incorporating ZnONPs. Int. J. Biol. Macromol. 2023, 224, 1322–1336. [Google Scholar] [CrossRef]
- AWPA E10-22; Laboratory Method for Evaluating the Decay Resistance of Wood-Based Materials against Pure Basidiomycete Cultures: Soil/Block Test. American Wood Protection Association: Clermont, FL, USA, 2022.

| Samples | WCAs (°) | ||
|---|---|---|---|
| 0 s | 3 s | 5 s | |
| E(Control) | 79 ± 1 a | 79 ± 1 a | 79 ± 1 a |
| E(CS) | 118 ± 1 b | 118 ± 1 b | 118 ± 1 b |
| E(TN) | 80 ± 1 c | 89 ± 1 a | 86 ± 1 a |
| E(AcOOH) | 54 ± 1 d | 45 ± 1 c | 41 ± 1 c |
| P(Control) | 17 ± 10 a′ | 17 ± 10 a′ | 17 ± 10 a′ |
| P(CS) | 124 ± 1 b′ | 124 ± 1 b′ | 123 ± 1 b′ |
| P(TN) | 80 ± 1 c′ | 68 ± 1 c′ | 61 ± 1 c′ |
| P(AcOOH) | 0 d′ | 0 d′ | 0 d′ |
| Samples | L* | a* | b* | ΔE | WI |
|---|---|---|---|---|---|
| E(Control) | 60 ± 4 a | 13 ± 4 a | 22 ± 3 a | 43 ± 4 a | 52 ± 4 a |
| E(AcOOH) | 54 ± 6 b | 13 ± 1 a | 19 ± 7 b | 46 ± 6 a,b | 50 ± 7 a |
| E(CS) | 44 ± 3 c | 12 ± 2 a | 13 ± 1 c | 53 ± 2 c | 41 ± 3 b |
| E(TN) | 50 ± 4 d | 13 ± 2 a | 15 ± 0 b,c | 49 ± 3 b | 45 ± 3 c |
| P(Control) | 74 ± 3 a′ | 5 ± 2 a′ | 21 ± 2 a′ | 30 ± 2 a′ | 66 ± 2 a′ |
| P(AcOOH) | 66 ± 4 b′ | 4 ± 0 a′ | 17 ± 2 b′ | 33 ± 2 a′ | 62 ± 3 b′ |
| P(CS) | 59 ± 6 c′ | 5 ± 1 a′ | 18 ± 2 c′ | 40 ± 5 b′ | 54 ± 5 c′ |
| P(TN) | 53 ± 5 d′ | 11 ± 2 b′ | 16 ± 1 b′ | 45 ± 4 c′ | 49 ± 4 d′ |
| Mass Gain (%) | |||||||
|---|---|---|---|---|---|---|---|
| P(control) | P(CS) | P(TN) | P(AcOOH) | E(control) | E(CS) | E(TN) | E(AcOOH) |
| 73 ± 5 | 63 ± 2 | 63 ± 5 | 67 ± 1 | 42 + 4 | 38 ± 5 | 34 ± 6 | 41 ± 16 |
| Samples | Leached Mass (%) |
|---|---|
| E(Control) | 9.0 ± 0.2 a |
| E(CS) | 7 ± 1 b |
| E(TN) | 6.5 ± 0.9 b |
| P(Control) | 8.4 ± 0.2 a′ |
| P(CS) | 7.2 ± 0.4 b′ |
| P(TN) | 7.0 ± 0.5 b′ |
| Chemical Solutions | Concentration (mg/mL) | AcOOH Concentration (%v/v) |
|---|---|---|
| CS | 5.0 | 1.0 |
| 2.0 | 1.0 | |
| 0.25 | 1.0 | |
| 0.125 | 1.0 | |
| 10 | 0.1 | |
| 10 | 0.5 | |
| TN | 2.0 | * |
| 0.5 | * | |
| 0.1 | * | |
| AcOOH | 2.1 | 2.0 |
| 1.1 | 1.0 | |
| 0.52 | 0.5 | |
| 0.11 | 0.1 | |
| 0.011 | 0.01 |
Disclaimer/Publisher’s Note: The statements, opinions and data contained in all publications are solely those of the individual author(s) and contributor(s) and not of MDPI and/or the editor(s). MDPI and/or the editor(s) disclaim responsibility for any injury to people or property resulting from any ideas, methods, instructions or products referred to in the content. |
© 2024 by the authors. Licensee MDPI, Basel, Switzerland. This article is an open access article distributed under the terms and conditions of the Creative Commons Attribution (CC BY) license (https://creativecommons.org/licenses/by/4.0/).
Share and Cite
Facchi, S.P.; de Almeida, D.A.; Abrantes, K.K.B.; Rodrigues, P.C.d.S.; Tessmann, D.J.; Bonafé, E.G.; da Silva, M.F.; Gashti, M.P.; Martins, A.F.; Cardozo-Filho, L. Ultra-Pressurized Deposition of Hydrophobic Chitosan Surface Coating on Wood for Fungal Resistance. Int. J. Mol. Sci. 2024, 25, 10899. https://doi.org/10.3390/ijms252010899
Facchi SP, de Almeida DA, Abrantes KKB, Rodrigues PCdS, Tessmann DJ, Bonafé EG, da Silva MF, Gashti MP, Martins AF, Cardozo-Filho L. Ultra-Pressurized Deposition of Hydrophobic Chitosan Surface Coating on Wood for Fungal Resistance. International Journal of Molecular Sciences. 2024; 25(20):10899. https://doi.org/10.3390/ijms252010899
Chicago/Turabian StyleFacchi, Suelen P., Débora A. de Almeida, Karen K. B. Abrantes, Paula C. dos S. Rodrigues, Dauri J. Tessmann, Elton G. Bonafé, Marcelo F. da Silva, Mazeyar P. Gashti, Alessandro F. Martins, and Lúcio Cardozo-Filho. 2024. "Ultra-Pressurized Deposition of Hydrophobic Chitosan Surface Coating on Wood for Fungal Resistance" International Journal of Molecular Sciences 25, no. 20: 10899. https://doi.org/10.3390/ijms252010899
APA StyleFacchi, S. P., de Almeida, D. A., Abrantes, K. K. B., Rodrigues, P. C. d. S., Tessmann, D. J., Bonafé, E. G., da Silva, M. F., Gashti, M. P., Martins, A. F., & Cardozo-Filho, L. (2024). Ultra-Pressurized Deposition of Hydrophobic Chitosan Surface Coating on Wood for Fungal Resistance. International Journal of Molecular Sciences, 25(20), 10899. https://doi.org/10.3390/ijms252010899











